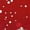
00A Red, variant on Christmas T Shirts - Crewneck 3/4 Sleeve Christmas Snowflake Women Tops 00H Blue

Best of SweatersBlack Lives Matter ClothingFleece ClothingJewelry & AccessoriesLoungewearRain GearTotal apparel wear to workWinter Puffer JacketsWomens Petite PlusAll Graphic ClothingAnimal PajamasBaby ClothesBags & AccessoriesBarbie ApparelBatman ClothingBeach AccessoriesBig and Tall Workout ClothingBig & Tall Pajamas and RobesBig and TallBig and Tall Hoodies and SweatshirtsBig and Tall ShirtsBig and Tall SuitsBig and Tall SweatersBig and Tall Work ClothingBlack ScrubsBlue Navy ScrubsBluey ClothingBoys Back to School FashionBoys ClothingBoys Coats and JacketsBoys School UniformsChrissy's Most LovedChristmas Onesie PajamasChristmas PajamasCoats and JacketsComfort ShoesCouples Christmas PajamasGirls Back to School FashionGirls ClothingGirls Coats & JacketsGirls School Uniform StoreGraphic TeesGreen ScrubsGrey ScrubsHalloween PajamasHanukkah Clothing & AccessoriesHarry Potter ClothingHats, Gloves & ScarvesHoliday ClothingJuniors ActivewearJuniors Dresses & RompersJuniors Graphic ClothingJuniors Graphic TeesJuniors PlusJuniors Plus SweatersJuniors Plus Sweatshirts & HoodiesJuniors Plus Tops & T-ShirtsJuniors SweatersJuniors Sweatshirts & HoodiesJuniors Tops & T-ShirtsKid's & Baby Cold Weather ClothingKids ActivewearKids Birthday OutfitsKids ClothingKids Coats & JacketsKids Fleece ClothingKids Graphic TeesKids New ArrivalsKids PajamasKids Shirts & TopsKids SweatersKids' Winter ClothingMatching Christmas PajamasMaternity ActivewearMaternity ClothesMaternity Coats & JacketsMaternity Plus SweatersMaternity Plus Sweatshirts & HoodiesMaternity Plus Tops & T-ShirtsMaternity SweatersMaternity SweatshirtsMaternity Tops & T-ShirtsMen's Winter ClothesMens Business CasualMens Coats and JacketsMens Fall OutfitsMens MultipacksMens Pajamas and RobesMens ShirtsMens ShoesMens ShortsMens SuitsMens SweatersMens Workout ClothingMens WorkwearMickey Mouse ClothingPeanuts ClothingPlaid PajamasPlus Size ActivewearPlus Size CoatsPlus Size DressesPlus Size ScrubsPlus Size SweatersPlus Size TopsPokemon ApparelPre-Owned Women's ClothingPremium Womens ClothingRunning Apparel and ShoesRunning ShoesSchool UniformsScrub TopsScrubsShoesSpider-Man ClothingStar Wars ClothingStranger Things ApparelToddler Back to School FashionToddler ClothingUnderscrubsValentine's PajamasVirtual try-on shop allWhite ScrubsWinnie the Pooh ClothingWomen's Bags & AccessoriesWomens ActivewearWomens Bras, Panties & LingerieWomens CoatsWomens DressesWomens Graphic TeesWomens Halloween PajamasWomens Pajamas & LoungewearWomens PantsWomens Petite Coats & JacketsWomens Petite SweatersWomens Petite Sweatshirts & HoodiesWomens Petites Tops & T-ShirtsWomens PlusWomens Plus Size Pajamas & LoungewearWomens Plus ThermalsWomens Plus Workwear & SuitsWomens ScrubsWomens ShoesWomens ShortsWomens SweatersWomens Sweatshirts & HoodiesWomens SwimsuitsWomens Thermal UnderwearWomens TopsWomens WorkwearYoung Adult ClothingYoung Men's Clothing
Best of SweatersBlack Lives Matter ClothingFleece ClothingJewelry & AccessoriesLoungewearRain GearTotal apparel wear to workWinter Puffer JacketsWomens Petite PlusAll Graphic ClothingAnimal PajamasBaby ClothesBags & AccessoriesBarbie ApparelBatman ClothingBeach AccessoriesBig and Tall Workout ClothingBig & Tall Pajamas and RobesBig and TallBig and Tall Hoodies and SweatshirtsBig and Tall ShirtsBig and Tall SuitsBig and Tall SweatersBig and Tall Work ClothingBlack ScrubsBlue Navy ScrubsBluey ClothingBoys Back to School FashionBoys ClothingBoys Coats and JacketsBoys School UniformsChrissy's Most LovedChristmas Onesie PajamasChristmas PajamasCoats and JacketsComfort ShoesCouples Christmas PajamasGirls Back to School FashionGirls ClothingGirls Coats & JacketsGirls School Uniform StoreGraphic TeesGreen ScrubsGrey ScrubsHalloween PajamasHanukkah Clothing & AccessoriesHarry Potter ClothingHats, Gloves & ScarvesHoliday ClothingJuniors ActivewearJuniors Dresses & RompersJuniors Graphic ClothingJuniors Graphic TeesJuniors PlusJuniors Plus SweatersJuniors Plus Sweatshirts & HoodiesJuniors Plus Tops & T-ShirtsJuniors SweatersJuniors Sweatshirts & HoodiesJuniors Tops & T-ShirtsKid's & Baby Cold Weather ClothingKids ActivewearKids Birthday OutfitsKids ClothingKids Coats & JacketsKids Fleece ClothingKids Graphic TeesKids New ArrivalsKids PajamasKids Shirts & TopsKids SweatersKids' Winter ClothingMatching Christmas PajamasMaternity ActivewearMaternity ClothesMaternity Coats & JacketsMaternity Plus SweatersMaternity Plus Sweatshirts & HoodiesMaternity Plus Tops & T-ShirtsMaternity SweatersMaternity SweatshirtsMaternity Tops & T-ShirtsMen's Winter ClothesMens Business CasualMens Coats and JacketsMens Fall OutfitsMens MultipacksMens Pajamas and RobesMens ShirtsMens ShoesMens ShortsMens SuitsMens SweatersMens Workout ClothingMens WorkwearMickey Mouse ClothingPeanuts ClothingPlaid PajamasPlus Size ActivewearPlus Size CoatsPlus Size DressesPlus Size ScrubsPlus Size SweatersPlus Size TopsPokemon ApparelPre-Owned Women's ClothingPremium Womens ClothingRunning Apparel and ShoesRunning ShoesSchool UniformsScrub TopsScrubsShoesSpider-Man ClothingStar Wars ClothingStranger Things ApparelToddler Back to School FashionToddler ClothingUnderscrubsValentine's PajamasVirtual try-on shop allWhite ScrubsWinnie the Pooh ClothingWomen's Bags & AccessoriesWomens ActivewearWomens Bras, Panties & LingerieWomens CoatsWomens DressesWomens Graphic TeesWomens Halloween PajamasWomens Pajamas & LoungewearWomens PantsWomens Petite Coats & JacketsWomens Petite SweatersWomens Petite Sweatshirts & HoodiesWomens Petites Tops & T-ShirtsWomens PlusWomens Plus Size Pajamas & LoungewearWomens Plus ThermalsWomens Plus Workwear & SuitsWomens ScrubsWomens ShoesWomens ShortsWomens SweatersWomens Sweatshirts & HoodiesWomens SwimsuitsWomens Thermal UnderwearWomens TopsWomens WorkwearYoung Adult ClothingYoung Men's Clothing